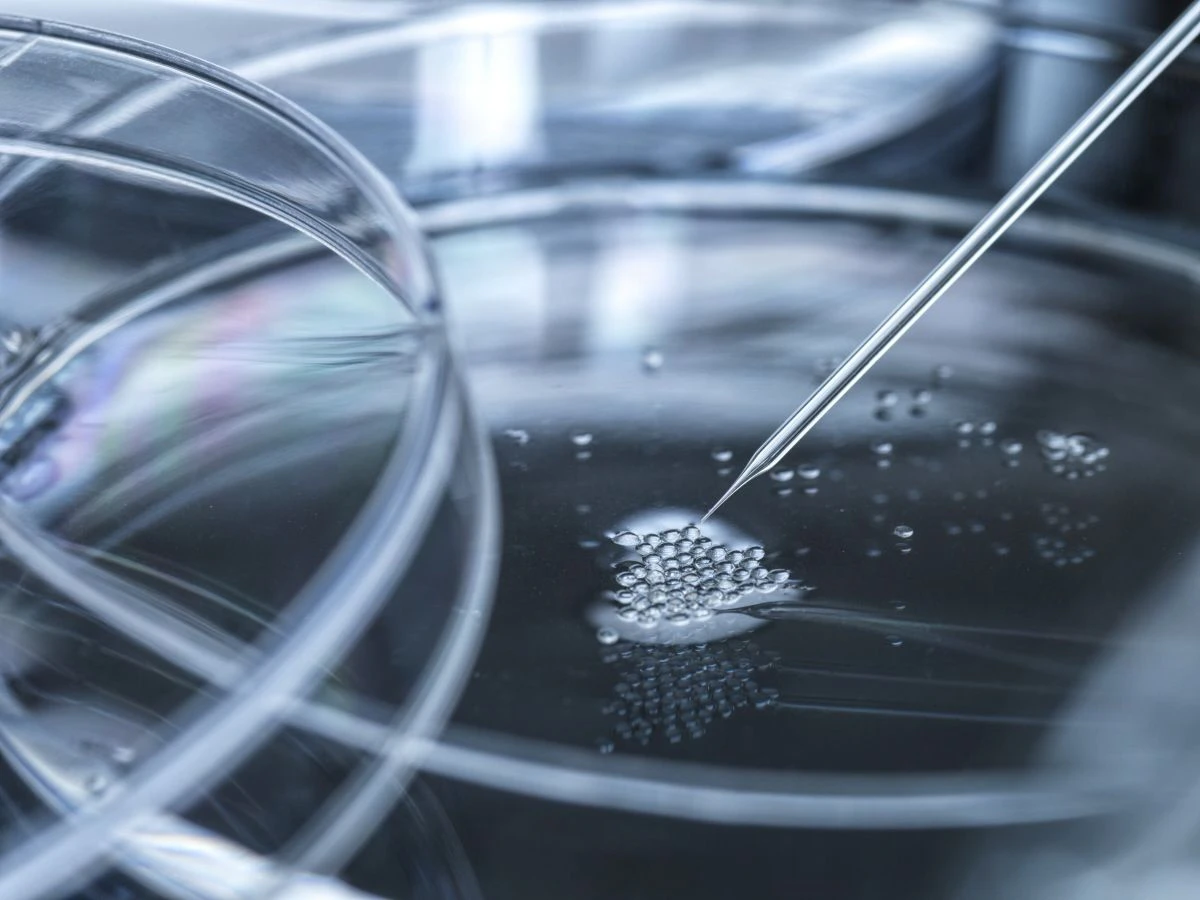

Forschergruppen melden, diesen Schritt vollzogen zu haben. Das klingt unheimlich. Obwohl mit lebenden Menschenklonen aus dem Labor vorerst nicht zu rechnen ist, fordern Ethiker eine breite ethische Debatte.
Aktuelles aus der Wissenschaft und Wissenschafts-Datenbank

Programmieren mit ChatGPT Von Klaus-Dieter Sedlacek Tauchen Sie in die Zukunft der Java-Entwicklung ein mit „ChatGPT: Der Game-Changer für Java-Entwickler“! Dieses Buch enthüllt die Bedeutung [...]

Leben wir im Innern einer Kugel? Autor: Ives, F. T. In dieser einfachen gemeinverständlichen Abhandlung werden einige von Wissenschaftlern aufgestellte Theorien überprüft und kritisiert sowie einige neue Theorien vorgestellt werden, die für den Verfasser plausibler sind. Es bedarf beispielsweise keiner langen Argumentation, um zu zeigen, dass Körper bei solchen Umdrehungen, wie sie die Erde macht, die Tendenz haben, durch die Zentrifugalkraft die schwereren Elemente nach außen zu schleudern, und da dies ein universelles Gesetz bei allen wissenschaftlichen Experimenten des Menschen [...]

Neuübersetzung 2023. Autor: Poincaré, Henri. In „Wissenschaft und Hypothese (frz. La Science et l’Hypothèse)“ wird eine tiefgründige Analyse der Wissenschaft und ihrer Beziehung zu Hypothesen [...]

mit einer Einführung von PROF. W. F. BARRETT, F.R.S. Ehemaliger Präsident der Gesellschaft für Psychische Forschung. Autor: Willson, Beckles. Als der Autor sich zum ersten Mal in das weite und neblige Gebiet des Paranormalen wagte, setze er mit leichtem Herzen und offenem Geist an. Sein einziges Ziel war es, mit den Mitteln, die einem gewöhnlichen Menschen mit wenig Mystik zur Verfügung stehen, herauszufinden, welcher Grad an Wahrscheinlichkeit mit den veröffentlichten Phänomenen verbunden ist, die die gewöhnlichen Naturgesetze, wie die meisten [...]

und wie der Zufall zu Entdeckungen führt. Autor: Cantor, Moritz. Was ist denn der Zufall? Ist der Eintritt eines Ereignisses Zufall, wenn es genauso gut auch hätte ausbleiben können? Und wenn ein Ereignis als Zufall gilt, was ist dann eigentlich Wahrscheinlichkeit? Wie manifestiert sich im Zufall eine Gesetzlichkeit nach der Art wie sich der Wind dreht? Kann man im scheinbar zufälligen Leben und Handeln der Menschen auch Gesetze im Zufall erkennen? Fragen über Fragen, aber der Mathematiker Dr. Moritz Cantor [...]

Einführung in die Erkenntnistheorie. Autor: Becher, Erich. Die Erkenntnistheorie ist als besonderes Gebiet der Philosophie die philosophische Grundwissenschaft, die aller Spekulation und aller Wissenschaft vorangehen muss. Diese Einführung hilft dabei, echte Erkenntnis zu gewinnen. [...]

Elementare Information und reiner Zufall im Nichts als Bausteine einer 4-dimensionalen Quanten-Welt. Autoren: Wrobel, Norbert; Sedlacek, Klaus-Dieter. Obwohl bereits vor mehr als hundert Jahren die Quantenphysik Gestalt annahm, setzte sich im Menschenbild eine mechanistische Vorstellung durch. Symbolisch dafür steht die Lehrtafel des Mediziners Fritz Kahn mit dem berühmten Motiv „Der Mensch als Industriepalast“. Mechanistische Vorstellungen über das Funktionieren eines Menschen halten praktisch bis zum heutigen Tag an. Nur langsam vollzieht sich ein Wandel im Denken, wie die Erklärungsversuche zu den [...]

Autor: Rutherford, Ernest. Das Verständnis des Aufbaus der Atome und der Atomkerne ist entscheidend, um die Welt verstehen. Mit einem besseren Verständnis der Kräfte in den Kernen und wie sie aufeinander wirken, können Forscher neue Technologien entwickeln, die uns helfen, unser Leben zu verbessern. Es kann uns beispielsweise ermöglichen, energiereichere Energiequellen als heutige fossil betriebene Kraftwerke herzustellen oder effizientere Wege finden, unsere Ressourcen im Alltag besser nutzen. Rutherford war einer der Ersten, der die Grundlagen der Kernphysik erforschte und dazu [...]

und Früchte vom Baum der Erkenntnis Autor: Bölsche, Wilhelm Wir sind dem wahren Geheimnis der Menschwerdung noch nie so nahe gewesen, als der Psychologe Wolfgang Köhler in dem kleinen Schimpansenparadies von Teneriffa bahnbrechende wissenschaftliche Studien an Schimpansen über den Werkzeuggebrauch im Tierreich durchführte. Gibt es Tiere, die menschengleich Früchte vom Baum der Erkenntnis gegessen haben? Es ist ein interessantes Thema, das sich zu lesen lohnt. [...]

Geschichte der Chemie. Autor: Ostwald, Wilhelm. Der visionäre Nobelpreisträger Wilhelm Ostwald, der den Übergang zur modernen wissenschaftlichen Chemie mitgestaltete, erzählt die aufregende Entwicklung seines Fachbereichs. Das Buch schließt mit einem Text über das Wesen der Katalyse ab, welche im organisch biologischen Bereich die Grundlagen aller Lebensvorgänge bildet und auch zur Lösung der Endlagerfrage von atomarem Abfall beitragen kann. Ein naturwissenschaftliches Abenteuer, das sich zu lesen lohnt. [...]

Das psychische Leben von Mikroorganismen - Eine Studie in experimenteller Psychologie. Autor: Binet, Alfred. Es gibt mikroskopisch winzige Lebewesen, die kein Gehirn haben und dennoch so etwas wie ein Gedächtnis. Diesen Lebewesen fehlen alle Sinnesorgane, dennoch können sie anscheinend sehen, hören, riechen und fühlen. Sie haben keine Arme oder Beine, dennoch können sie laufen und bei Bedarf so etwas wie Ärmchen nachbilden, um sich damit das zu greifen, was sie wollen. Sie können jagen, sich verteidigen, ja sie haben sogar [...]

Wahrscheinlichkeiten abschätzen. Autor*innen: Sedlacek, Klaus-Dieter (Hrsg.) Dieses Buch hilft, Wahrscheinlichkeiten besser beurteilen zu können. Zum Inhalt: - Wie einfache Überlegungen zu den Grundprinzipien von Vorhersagen führen - Die Klassenlotterie - Die Grundlage der Lebensversicherung - Können Verbrechen vorhergesagt werden? - Anwendung der Vorhersagen auf dem Gebiet der Naturwissenschaft [...]

Historische Erzählung. Autor: Colerus, Egmont. Die historische Erzählung handelt davon, wie vor 2200 Jahren der geniale Mathematiker und Mechaniker Archimedes die nach ihm benannte Spirale erfand. Eine ägyptische Muse, zu der er eine Beziehung hatte, brachte ihn auf die Idee, wie man durch Muskelkraft und mithilfe der Spirale Wasser durch ein hölzernes Rohr auf ein höhergelegenes Niveau zur Bewässerung der Felder anheben konnte. Vorausgegangen waren zahlreiche weitere Erfindungen und Erlebnisse aus der damaligen Zeit, die das Buch zu einer interessanten [...]

Sechs Vorträge. Autor: Schleich, Carl Ludwig. Schleich gibt in diesem Werk als Erster eine physiologische Darstellung der Vorgänge, welche zu einem Ichgefühl führen. Ihm steht als erfahrener Mediziner das Experiment der Narkose zur Seite, um für diese Art von Geistigkeit eine anatomisch-physiologische Basis zu finden. Mit Schleich werden wir einem größeren Wunder begegnen: der Individualität. [...]

Neue Erkenntnisse über die Gestalten biotechnischer Systeme der Welt. Autor: Francé, Raoul H. Seit Jahrtausenden ist die Menschheit bestrebt, die Welt, in der sie lebt, erkennen und verstehen zu lernen. Die Erfahrung führt zu einem wachsenden Tatsachenmaterial und die zunehmende Erkenntnis zu einem sich fortwährend verändernden Weltbild. Jahrzehntelang sind es fast ausschließlich die Biologen gewesen, die sich an die Aufgabe der Aufstellung eines einheitlichen Weltbilds herangewagt haben, Botaniker und Zoologen, Anatomen und Physiologen. Die exakten Naturforscher haben sich dagegen lange [...]

Fantastische Einblicke in andere Welten. Autor: Proctor, Richard A. Die Mythen und Wunder der Astronomie sind eine faszinierende Kraft, die uns in unergründliche Welten eintauchen lässt. Dieses Buch befasst sich mit einigen der bemerkenswertesten Aspekte der Astronomie, von den alten Mythen über die Kraft der Himmelszeichen bis hin zu den Theorien über die Existenz anderer Welten und anderer Universen. In jedem Kapitel werden die interessantesten und wunderbarsten Aspekte der Astronomie mit wissenschaftlichen Erkenntnissen verknüpft und jedes der Kapitel hat seine [...]

Autor: Markoff, A. A. In diesem Buch entwickelt der Autor die Wahrscheinlichkeitsrechnung als eine mathematische Disziplin, ohne sich mit ausführlicher Betrachtung ihrer mehr oder weniger wichtigen Anwendungen zu befassen. Ohne lange Erwägungen über die Grundlagen der Wahrscheinlichkeitsrechnung anzustellen, bemüht sich der Autor, klar die Annahmen aufzustellen, welche für die Begründung bekannter Theorien nötig sind. Gleichzeitig vermeidet er nach Möglichkeit überflüssige Annahmen, auch wenn sie allgemein anerkannt werden und er vermeidet auch zweifelhafte Überlegungen, besonders wenn sie in die Form mathematischer [...]

Autor: Hensel, Kurt. Als die Aufgabe der elementaren Zahlentheorie kann die Aufsuchung der Beziehungen bezeichnet werden, welche zwischen allen rationalen ganzen oder gebrochenen Zahlen m einerseits und einer beliebig angenommenen festen Grundzahl g andererseits bestehen. Man kann dieser Aufgabe in ihrem weitesten Umfange dadurch genügen, dass man alle diese Zahlen m in unendliche Reihen entwickelt. Nur durch die Betrachtung dieser vollständigen Reihen erhält man eine vollkommene Lösung unserer Aufgabe; beschränkt man sich dagegen auf gewisse Anfangsglieder derselben, wie dies gewöhnlich [...]

Und ihre Anwendungen - Eine Theorie des Überlebensmechanismus. Autor: Carington, Walter Whately. Whately Carrington, ein prominenter Erforscher des Paranormalen aus dem frühen 20. Jahrhundert nimmt sich seltsamer und wunderbarer Themen an und stellt Fragen wie... . Gibt es Dimensionen jenseits derer, die wir ohne weiteres beobachten können? Wie kann unser Bewusstsein in höhere Dimensionen vordringen? . Welche Rätsel kann die psychische Forschung lösen? . Was ist Zeit, und wie können wir sie überwinden? . Wo überschneidet sich die Religion mit [...]

Die unmittelbaren Gegebenheiten des Bewusstseins. Autor: Bergson, Henri. Zeit und Willensfreiheit: Ein Essay über die unmittelbaren Gegebenheiten des Bewusstseins (französisch: Essai sur les données immédiates de la conscience) ist Henri Bergsons Doktorarbeit, die erstmals 1889 veröffentlicht wurde. Der Essay befasst sich mit dem Problem des freien Willens, das nach Bergson lediglich eine unter Philosophen weit verbreitete Verwechslung ist, die durch eine unzulässige Übertragung des Unausgedehnten auf das Ausgedehnte verursacht wird, und dient als Mittel zur Einführung seiner Theorie der Zeitdauer, [...]

Autor: Boole, George. Das Logik-Kalkül von Boole ist ein Formalismus, der von George Boole entwickelt wurde, um die Logik in algebraischer Form darzustellen. Mit diesem Formalismus können Aussagenlogik und Wahrscheinlichkeitstheorie mathematisch analysiert werden. Boole'sche Algebra (auch als Boolean Algebra bezeichnet) ist die Grundlage für viele Bereiche der modernen Mathematik und Computerwissenschaften, insbesondere im Bereich der Informatik und der Schaltkreistechnik. Das Boole'sche Kalkül ermöglicht es, komplexe logische Verknüpfungen zu analysieren und zu optimieren, was für die Entwicklung von Schaltungen und Algorithmen [...]

Erklärungen, Theorien und Lehrmeinungen. Autor: Flammarion, Camille. Dieses faszinierende Werk, verfasst von Camille Flammarion, einem talentierten und anerkannten Astronomen, stellt ein umstrittenes Thema dar, den [...]

Über die Idee des Fortschritts, die Entstehung und Entwicklung. Autor: Bury, J. B. „Zivilisation und Fortschritt: Über die Idee des Fortschritts, die Entstehung und Entwicklung [...]

Der Zusammenhang zwischen Physis und Psyche. Autor: Valier, Max. In dem Buch "Das transzendentale Gesicht der Welt" geht es um eine bisher unbekannte Wellengattung, die psychophysische Welle, welche eine Verbindung der physischen mit der psychischen Welt darstellt. Um ein volles Verständnis der dargelegten Experimente zu bekommen, welche die Existenz der psychophysischen Welle bestätigen, führt der Verfasser den Leser im ersten Hauptteil in die dazugehörige naturphilosophische Theorie ein, erklärt im zweiten Hauptteil, die Experimentiermöglichkeiten, um dann im dritten Hauptteil zu erläutern, [...]

Mathematik für Jedermann. Autor: Colerus, Egmont Colerus nimmt die dankenswerte, aber auch schwierige Aufgabe auf sich, Freunde und Feinde der Mathematik zu versöhnen. Es gibt eine große Anzahl Menschen, die sich konstitutionell für unfähig halten, sich für Mathematik zu begeistern. Für solche wurde dieses Buch geschrieben, nicht von einem Mathematiker, sondern von einem Künstler der Worte. Aus einer souveränen Beherrschung der Materie heraus hat Colerus diese Aufgabe unternommen und jeder Leser wird ihm für die schönen Gleichnisse und Bilder, den [...]

Wasserstoff, Solarzellen und Kernfusion - Pressemeldungen zum Stand der Forschung. Hrsg.: Sedlacek, Klaus-Dieter (Hrsg.). Wie sieht die Energie der Zukunft aus nach dem Ende fossiler Energien? Wie weit ist die Forschung und ggf. auch die Einführung neuer Technologien um eine grundlegende Energiewende zu ermöglichen? Oder sind wir möglicherweise noch länger auf fossile Energien angewiesen? Wichtige Informationen zur Beantwortung dieser Fragen geben uns ausführliche Pressemeldungen aus erster Quelle, nämlich aus Wirtschaft und Wissenschaft. Leseprobe: [...]

Das Geheimnis hinter den Erscheinungen der Welt. Autor: Sedlacek, Klaus-Dieter (Hrsg.). Was uns an den beinahe mythischen Denkern der antiken Welt so fasziniert, ist die wundervolle, abgeschlossene Einheit ihres Weltbildes. Mit welcher prachtvollen Gebärde steht einer dieser Denker vor uns, der legendenumrankte Pythagoras etwa, und sagt mit kühlem, unbeirrbarem Blick: Ich halte das Weltgeheimnis in den Händen.Und hier beginnen die Ziele des vorliegenden Werkes. Es erblickt seine Aufgabe darin, in einem Umfang, der sich noch durcharbeiten lässt, ein wirkliches Verständnis [...]

Geschichte der Mathematik für jedermann. Autor: Colerus, Egmont. Colerus ist der berufene Autor, der die Epochen der Mathematik darzustellen vermag. Nur er hat die Gabe, wissenschaftliche Dinge so darzustellen, dass sie jedermann versteht und begeistert wird. An entscheidenden, sorgfältig ausgewählten Persönlichkeiten werden die Entwicklungsstufen der Mathematik aufgewiesen in stetem Zusammenhang mit den allgemeinen historischen, vor allem kulturhistorischen Entwicklungslinien. Das Buch wird dadurch äußerst reizvoll und interessant. Eine ganz eigene Geschichte der Mathematik. Besonders kommen klar die Unterschiede der einzelnen Völker [...]

Materialisations-Experimente mit M. Franek-Kluski. Autor*innen: Sedlacek, Klaus-Dieter; Schrenck-Notzing, A. Freiherrn von. Die vorliegende Schrift beschäftigt sich mit speziellen physikalischen Phänomenen, nämlich der durch Versuchspersonen verursachten Materialisation von Objekten. Das tatsächliche Vorkommen dieser Phänomene wird untersucht, um eine dem naturwissenschaftlichen Denken angepasste Erklärung zu finden. [...]

Die Top10-Physiker der Menschheitsgeschichte. Hrsg.: Sedlacek, Klaus-Dieter (Hrsg.). Den meisten Menschen sind Schöpfer von Kunst und Literatur vertraut, sie kennen unsere Staatslenker und Wirtschaftsführer, doch wer kennt die Giganten der Physik und ihre fundamentalen Leistungen für unsere westliche Kultur? Die zahllosen Wunder, welche die exakte Naturwissenschaft der vergangenen Jahrhunderte hervorgebracht hat, scheinen vielen Menschen heute als selbstverständlich. Doch sind sie das? Die Errungenschaften unserer hoch entwickelten Technik werden konsumiert, doch auf welchem Fundament wurde diese Technik errichtet?Was der menschliche Geist [...]

Die elegante Frau vom 18. bis ins 20. Jahrhundert. Autorin: Aretz, Gertrude. Die Kunst und die Lust zu gefallen, anzuziehen und mit besonderer Betonung aller Reize zu verführen, sind in der Geschichte der Frau so alt wie die Welt selbst. Zu allen Zeiten und in allen Ländern ist und war der Kult der Schönheit der Ausdruck höchster Kultur. Je mehr ein Volk Kultur besitzt, desto größer ist der Luxus, desto verfeinerter und raffinierter der Geschmack in allen Dingen der Körperpflege [...]

Geschichte der Chemie. Autor: Ostwald, Wilhelm. Einführend berichtet Justus Liebig, wie die voller Geheimnisse steckende Alchemie die Grundlagen der heutigen Chemie geschaffen hat. Der visionäre Nobelpreisträger Wilhelm Ostwald, der den Übergang zur modernen wissenschaftlichen Chemie mitgestaltete, erzählt dann in sieben Kapiteln die aufregende Entwicklung seines Fachbereichs. Das Buch endet mit einem Text über das Wesen der Katalyse, welche im organisch biologischen Bereich die Grundlagen aller Lebensvorgänge bildet und mit einem Beitrag über die Transmutation von Elementen, die zur Lösung der [...]

Eine populäre Erläuterung der berühmten Theorie (Neuübersetzung). Autor: Nordmann, Charles. Einsteins Theorien haben eine tiefgreifende Revolution in der Wissenschaft herbeigeführt. In ihrem Licht erscheint die Welt einfacher, koordinierter, einheitlicher. Wir werden von nun an besser erkennen, wie großartig und kohärent sie ist, wie sie von einer unnachgiebigen Harmonie beherrscht wird. Ein wenig von dem Unaussprechlichen wird uns klarer werden. M. Nordmann hat eine populäre Erläuterung der berühmten Einsteinschen Theorie hingezaubert und das Einsteinsche Prinzip in Worten dargestellt, die den durchschnittlichen [...]

Komet und Weltuntergang: Die Gefahr aus dem All. Autor: Bölsche, Wilhel. Als 2006 der erdbahnkreuzende Komet 73P/Schwassmann-Wachmann 3 in einige Stücke zerbrach, war dies der Bild-Zeitung einen schaurigen Bericht unter dem Titel "Komet rast auf Erde zu - Forscher in großer Sorge - 200 Meter hohe Flutwelle im Atlantik?" wert. In manchen unserer Medien oder bei sogenannten Katastrophen-Propheten besteht das Bedürfnis, den Weltuntergang nicht nur durch den Klimawandel, sondern auch infolge eines Zusammenstoßes der Erde mit einem Kometen zu proklamieren. [...]

4000 Jahre Pionier-Arbeit. Autor: Darmstaedter, Ludwig. Die Chronologie der Exakten Wissenschaften umfasst die Entwicklung der empirischen und systematischen Erforschung der Natur von der Frühgeschichte bis zum Wechsel ins zwanzigste Jahrhundert. Das menschliche Erkennen der Natur führte zunehmend zur Naturbeherrschung. Das Erkenntnis-Potential nahm im Laufe der Geschichte stark zu und verstärkte den Fortschritt in der Naturerkenntnis. In immer schnellerer Folge wurden Erfindungen und Entdeckungen gemacht. Die chronologische Darstellung dieses Buchs konzentriert sich auf diese zeitliche Folge. Ergänzend lässt sich über ein [...]

Natürliche Grundlagen einer Theorie des evolutiven Quantenbewusstseins. Autoren: Wrobel, Norbert; Sedlacek, Klaus-Dieter. Seltsam sind die physikalischen Gesetze, die unsere Welt wirklich beherrschen: Es sind die Gesetze einer makroskopischen Quantenwelt, in der alles Seiende dazu beiträgt, eine materiehaltige Wirklichkeit zu erzeugen. Die Verbindung unserer realen, 4-dimensionalen Welt mit dem jenseitig Abstrakten erfordert einen physikalischen Prozess, der evolutionär weiterentwickeltes Bewusstsein auf elementarer Ebene voraussetzt. Die Wirklichkeit, in der wir leben, würde vom Quantenzufall aus elementarer Information erzeugt werden, so das Ergebnis des [...]

Das Gesetz im Zufall. Autor: Cantor, Moritz. Zufall wurde es Jahrhunderte lang genannt, wenn der Wind von Süd nach Südwest, von Nord nach Nordost umzuschlagen pflegte und nicht etwa die entgegengesetzte Veränderung eintrat. Da veröffentlichte der Begründer der heutigen Meteorologie, der Physiker Heinrich Dove, das nach ihm benannte Winddrehungsgesetz, und von Zufall redet niemand mehr. Was ist aber dann der Zufall? Ist der Eintritt eines Ereignisses Zufall, wenn es genauso gut auch hätte ausbleiben können? Kann man im scheinbar zufälligen [...]

Die Tarner-Vorlesungen gehalten am Trinity College. Autor: Whitehead, Alfred North. Alfred North Whiteheads „Das Wesen der Natur“ revolutioniert das Denken über den Umgang der Naturwissenschaften [...]

Praxisnah, kurz und prägnant. Autor: Sedlacek, Klaus-Dieter. Entdecken Sie „IT- und KI-Grundwissen für Einsteiger“ von Klaus-Dieter Sedlacek – das perfekte Buch, um in die Welt [...]

Space-time Phenomena Evidence And Visions. Author: Sedlacek, Klaus-Dieter. Thirty-five top-class scientists have a vision. They meet in seclusion and want to learn about the immortality of consciousness and the meaning of life. In the end, the sensational result is: There is an afterlife! Seemingly inexplicable phenomena are not only listed, but put into a big context and explained in a comprehensible way. 26 illustrations in the text make for clarity. This non-fiction book describes in a concrete and credible way [...]

In welcher Form existiert ein Weiterleben nach dem zeitlichen Ende? Autor*innen: Ostwald, Wilhelm. Das hier veröffentlichte Buch ist die deutsche Übersetzung eines Vortrages, den der Nobelpreisträger Wilhelm Ostwald an der Harvard-Universität in den Vereinigten Staaten gehalten hat. Der Vortrag folgte der Bestimmung, dass er sich auf die Unsterblichkeit des Menschen beziehen, und dass die Wahl des Vortragenden nicht durch sein religiöses Bekenntnis oder seinen Beruf beschränkt sein soll, damit die Wahrheit durch eine möglichst allseitige Behandlung des Problems zutage treten [...]

Das Wesen der Naturgesetze. Autor: Schlick, Moritz. Die Naturphilosophie verhält sich zur Naturwissenschaft wie die Philosophie im Allgemeinen zur Wissenschaft überhaupt. So ist es die Aufgabe der Naturphilosophie, für das Gebiet der naturwissenschaftlichen Erkenntnis einen wesentlichen Beitrag zu leisten. Es sind jene Fragen, die auf die Klärung oberster Begriffe zielen, wie Materie, Kraft, Raum und Zeit, Gesetz, Leben: Begriffe, die beinahe in jede Aussage über Naturdinge und Naturgeschehen irgendwie eingehen. Diese wesentlichsten Probleme bilden für den Naturforscher selber stets das [...]

Eine vergleichende experimentelle Untersuchung über die Entstehung von Technik und Kunst. Autor: Dennert, Eberhard. Die Erforschung des Urmenschen hat in den letzten Jahrzehnten einen ganz ungeahnten Aufschwung genommen und zwar besonders durch einige sehr glückliche Funde in Südfrankreich, das dadurch geradezu zum klassischen Land des Urmenschen geworden ist. Dieses Buch enthält nun eine vergleichend-experimentelle Untersuchung über die geistige Entwiclung dieses Urmenschen. Das Ergebnis wird manchen Leser in hohem Grade überraschen. Der Autor bekennt ganz offen, daß es auch ihn außerordentlich [...]

Eine kurze und prägnante Einführung. Autor: Kirchberger, Dr. Paul. Form und Inhalt des vorliegenden Bändchens bestimmen sich dadurch, das es eine in sich abgerundete und verständliche Darstellung seines Gegenstandes sein will. Von den zahlreichen Anwendungen der Quantentheorie werden vornehmlich diejenigen behandelt, die auf das Atommodell Bezug haben. Mathematische Entwicklungen hat der Autor möglichst vermieden. Einige, an denen er im Interesse tieferen Verständnisses nicht glaubte, vorübergehen zu sollen, wird der hierfür nicht zugängliche Leser ohne allzu großen Schaden überschlagen können. So [...]

Strukturen der Selbstorganisation in Natur und Technik. Hrsg.: Sedlacek, Klaus-Dieter. Das Universum erschien bis ins 19. Jahrhundert wie ein ablaufendes mechanisches Uhrwerk. Der Schock kam im frühen 20. Jahrhundert mit dem Aufkommen der Quantenmechanik. Die Anwendung der klassischen Gesetze auf Atome führte zu hoffnungslos falschen Ergebnissen. Atome verhalten sich überhaupt nicht wie Billardkugeln: Flüssigkeiten und Feststoffe sind ein Zusammenschluss von Quantenobjekten zu makroskopischen Substanzen, aber ihre Eigenschaften flüssig oder fest lassen sich nicht von den Eigenschaften einzelner Quanten ableiten. Sie [...]

und Naturwissenschaft. Autoren: Sedlacek, Klaus-Dieter; Schlick, Moritz. Es die Aufgabe der Naturphilosophie, für das Gebiet der naturwissenschaftlichen Erkenntnis einen wesentlichen Beitrag zu leisten. Es sind jene Fragen, die auf die Klärung oberster Begriffe zielen, wie Materie, Kraft, Raum und Zeit, Gesetz, Leben: Begriffe, die beinahe in jede Aussage über Naturdinge und Naturgeschehen irgendwie eingehen. Diese wesentlichsten Probleme bilden für den Naturforscher selber stets das Ziel, auf das sein Auge gerichtet bleibt, und für den Laien sind sie fast das Wichtigste, [...]

Autor: Driesch, Hans. Mit den »mystischen«, »irrationalen« Neigungen hat die Parapsychologie gar nichts zu tun. Sie ist Wissenschaft, ganz ebenso, wie Chemie und Geologie Wissenschaften sind. Unmittelbar »schauen« tut sie gar nichts, sie arbeitet positivistisch und induktiv. Sie findet Typen oder Formen des Weltgeschehens wie jede andere Wissenschaft; ihre Arbeit ist durchaus »rational«. Die Parapsychologie steht somit im Dienst echter Aufklärung, denn rational arbeiten heißt »aufklärend« arbeiten. Es handelt sich um ein Standardwerk dieses Fachbereichs, das sich zu lesen lohnt. [...]

Aufgedeckte Naturgeheimnisse. Autor: Laßwitz, Kurd. In diesem Buch nimmt der Autor Stellung zu Fragen folgender Art: Lässt uns die Natur in ihre Werkstatt blicken? Wie hängen Bewusstsein und Natur zusammen? Was ist unvergänglich in Raum und Zeit? Ist die Welt dem Untergang geweiht? Wie wird die Zukunft werden? Ein Buch das sich zu lesen lohnt! [...]

Wie Enzyme, Bewusstsein und quantenbiologische Effekte das Leben regulieren. Autoren: Sedlacek, Klaus-Dieter; Wrobel, Norbert. Der Begründer der Quantenmechanik und Nobelpreisträger Erwin Schrödinger beschäftigte sich unter anderem mit der Frage: "Was ist Leben?" Er vermutete, dass Leben etwas mit der Quantenwelt zu tun hat. Offensichtlich ist die Dynamik des Lebens fein ausbalanciert zwischen dem, was sich auf der Quantenebene abspielt, über die Biochemie der Zellen bis hin zum makroskopischen Organismus und seiner Organisation. Zielgerichtetes und bedarfsgerechtes Ausnutzen quantenphysikalischer Phänomene, wie Tunneleffekte, [...]

In Neusatz und aktueller Rechtschreibung. Autor: du Prel, Carl. Der Spiritismus ist ohne Zweifel die paradoxeste aller Wissenschaften und er wird es wohl noch lange bleiben. Das liegt offenbar nur daran, dass ihm alle verbindenden Fäden mit dem, was heute als Wissenschaft anerkannt ist, zu fehlen scheinen, ja dass er der heutigen Wissenschaft zu widersprechen scheint. In Wirklichkeit ist das allerdings nicht der Fall. Es existieren Fäden, die den Spiritismus mit anderen Wissenszweigen verbinden. Der Autor will die Lücke ausfüllen, [...]
Forschergruppen melden, diesen Schritt vollzogen zu haben. Das klingt unheimlich. Obwohl mit lebenden Menschenklonen aus dem Labor vorerst nicht zu rechnen ist, fordern Ethiker eine breite ethische Debatte.

Wie man im Verkauf und im Leben erfolgreich sein kann. Autor: Hawkins, Norval A. Jeder kann, ungeachtet der Umstände, immer Erfolg haben. Dieses Buch zeigt Ihnen, wie. Der Schlüssel dazu besteht darin, die Faktoren des Scheiterns zu vermeiden und durch Merkmale des Erfolgs zu ersetzen. Norval A. Hawkins befasst sich [...]

Sachbuch von Emil Lucka. Das Werk „Die Evolution der Liebe“ ist ein kraftvolles Manifest, das sich zum Ziel gesetzt hat, die primären Ausprägungen der Liebe [...]

Die Tarner-Vorlesungen gehalten am Trinity College. Autor: Whitehead, Alfred North. Alfred North Whiteheads „Das Wesen der Natur“ revolutioniert das Denken über den Umgang der Naturwissenschaften [...]

Effektives CMS mit modernen TOLERANT Softwarelösungen „Compliance Management System (CMS)“ von Klaus-Dieter Sedlacek ist ein praxisorientiertes Handbuch, das Unternehmen hilft, gesetzliche und regulatorische Anforderungen zu [...]

Erklärungen, Theorien und Lehrmeinungen. Autor: Flammarion, Camille. Dieses faszinierende Werk, verfasst von Camille Flammarion, einem talentierten und anerkannten Astronomen, stellt ein umstrittenes Thema dar, den [...]

und meine Rückkehr nach vielen Tagen Von Cora L. V. Richmond „Meine Erfahrungen außerhalb meines Körpers und meine Rückkehr nach vielen Tagen“ von Rev. Cora [...]

Chancen, Risiken und der Stand der Technik Das Buch „Künstliche Intelligenz heute: Chancen, Risiken und der Stand der Technik“ von Klaus-Dieter Sedlacek bietet eine umfassende [...]

Mythen aus Babylonien und Assyrien. Autor: Mackenzie, Donald A. „Unendliche Weisheiten“ – Diese Worte beschreiben Donald Alexanders Mackenzies fesselndes Sachbuch über Babylonien und Assyrien. Der [...]

John Dewey, einer der einflussreichsten amerikanischen Philosophen und Begründer des Pragmatismus, präsentiert in „Neuausrichtung der Philosophie“ eine bahnbrechende Rekonstruktion der philosophischen Gedankenwelt. Dieses Werk, ursprünglich [...]

und der Meinungsäußerung. Die „Geschichte der Gedankenfreiheit“ ist ein faszinierendes Buch, das den Leser auf eine Reise durch die Jahrhunderte mitnimmt. Der Autor J.B.Bury erzählt [...]

David Livingstone, der berühmte schottische Missionar und Entdecker, unternahm zwischen 1858 und 1864 eine bedeutende Expedition zum Zambesi. Während dieser Reise erforschte er die natürlichen [...]

Mögliches und Unmögliches. Autor: Leacock, Stephen. Der Buchtext beschreibt die schlechte Lage der Welt und die unterschiedlichen Meinungen darüber, wie das Problem angegangen werden sollte. Professor Leacock ist der Meinung, dass das Problem tief verwurzelt ist und den Zusammenbruch des traditionellen Wirtschaftssystems bedeutet. Er warnt vor der Versuchung, in den [...]

Geschichte antiker Reiche. Autor: Seignobos, Charles. „Die Wiege der Zivilisation – Geschichte antiker Reiche“ von Charles Seignobos ist eine faszinierende Erkundung der Ursprünge und der [...]

Paradies der Damen, die Graphic Novel-Adaption von Émile Zolas gleichnamigem Roman, ist ein Meisterwerk, das sowohl literarische Tiefe als auch visuelle Schönheit vereint. Die Geschichte [...]

Fantastische Einblicke in andere Welten. Autor: Proctor, Richard A. Die Mythen und Wunder der Astronomie sind eine faszinierende Kraft, die uns in unergründliche Welten eintauchen lässt. Dieses Buch befasst sich mit einigen der bemerkenswertesten Aspekte der Astronomie, von den alten Mythen über die Kraft der Himmelszeichen bis hin zu den [...]

Der Weg zu mehr Umsatz – Komplettleitfaden für IT-Unternehmen. Klaus-Dieter Sedlacek, ein Meister seines Fachs in der Welt des Marketings und der digitalen Strategie, bietet [...]

und der B-Strahl. Autor: Leblanc, Maurice. Im Labor des alten Wissenschaftlers Noël Dorgeroux tauchen ungewöhnliche, animierte Visionen auf, die Szenen aus der Gegenwart und der Vergangenheit zeigen, jeweils mit dem geometrischen Bild von drei Figuren oder Augen in den Ecken eines Dreiecks. Sein Neffe, Victorien Beaugrand, der später die Visionen [...]

Vedanta-Philosophie. Autor: Abhedananda, Swami. Entdecken Sie die faszinierende Welt der Reinkarnation mit „Fünf Vorträge über Reinkarnation“. In diesem Buch werden Sie von einem der führenden [...]

Weisheit des Ostens. Autor: Brönnle, Paul. Erleben Sie die Welt des arabisch-andalusischen Gelehrten Ibn Tufail hautnah und tauchen Sie ein in sein bedeutendstes Werk „Das [...]

oder unsere androzentrische Kultur. Autorin: Perkins Gilman, Charlotte. In dieser Kritik der "androzentrischen Kultur" untersucht die Pionierin und Feministin Charlotte Perkins Gilman mit Witz und Einfühlungsvermögen die vielen negativen Auswirkungen der männlichen Vorherrschaft auf die Frauen sowie das Wohlergehen der Menschheit als Ganzes. Die lange Geschichte der männlichen Vorherrschaft und [...]

Kräftige und Feinschmecker-Gerichte für Freizeit und Camping. Hrsg.: Sedlacek, Klaus-Dieter. Dieses Buch liegt vielleicht nicht im Trend von Diätkochbüchern und Fernsehkoch-Rezepten, aber es hat einen unschätzbaren Vorteil, es verspricht für Feinschmecker und Freunde von kräftigen Gerichten den Zugang zu ungeahnten Geschmackswelten zu öffnen. Das erreicht es durch einige wenige einfache [...]

Eine Studie über Magie und Religion. Von Sir James George Frazer. Entdecken Sie die faszinierende Welt der Magie und Religion in „Der goldene Zweig: Eine [...]

Die detaillierte Rezension des Buches Gut und Böse – Macht und moralische Konflikte unserer Zeit von Leonhard Stein, das tief in die Wechselwirkungen von Moral, [...]

Autor: McMurry, Frank M. Der Autor hat sich intensiv mit der Frage beschäftigt, wie man Erwachsenen beibringen kann, Kindern das Lernen beizubringen. Die Ideen, die er hier vorstellt, stammen größtenteils aus Beobachtungen, Experimenten und Diskussionen mit seinen Studenten. Er hat versucht, jede gute Anregung, die von seinen Studenten kam, zu [...]

Mystery-Krimi. Autor: Collins, Wilkie. Als im Herbst 1870 die französischen und deutschen Armeen in einen blutigen Krieg verwickelt sind, schlägt eine Granate in das Haus [...]

Mystische Traditionen offenbaren tiefste Wahrheiten. Autor: Maeterlinck, Maurice. „Maurice Maeterlinck – Das große Geheimnis“ ist ein faszinierendes und tiefgründiges Buch, das sich mit den philosophischen [...]

Grundsätze und Anwendung der Montessori-Methode zum Selbstlernen der Kinder. Autor: Montessori, Maria. Dies ist ein Leitfaden für die Verwendung der Montessori-Materialien im Klassenzimmer. Es zeigt, [...]

Nach der Methode von Emile Coué. Autor: Brooks, C. Harry. Erreiche die Kontrolle über dein Leben. Der Autor begleitet den Leser in seinem Buch „Die [...]

In Ein Buch der Entdeckungen: Die Geschichte der Erforschung der Welt, von den frühesten Zeiten bis zur Entdeckung des Südpols erzählt uns Autorin M. B. Synge eindrucksvoll von den berühmtesten Entdeckern und Forschern, die uns helfen, die Welt besser zu verstehen. Beginnend bei den Reisen in der Antike über die [...]

Autorin: Max du Veuzit. Willkommen auf dem düsteren Anwesen von Malbackt, wo nichts ist, wie es scheint. Die junge Marguerite, eine Waise, findet Zuflucht bei [...]

Wie man sein Schicksal in einer Teetasse lesen kann. Autor*in: Kent, Cicely. Das Buch "Wahrsagen anhand von Teeblättern" bietet eine Einführung in die Praxis und Theorie des Lesens der Teetasse. Die verschiedenen Symbole und Kombinationen von Symbolen werden erläutert und Beispieltassen mit ihren Interpretationen präsentiert. Es gibt viele Gründe, warum [...]

Autor: Benson, Allan L. Die Zeitung New York Globe schreibt: Viele Schriftsteller haben die Wahrheit über den Sozialismus gesagt, aber nicht viele haben sie so rassig und mit so viel Feuer und ohne Umschweife gesagt wie Herr Benson ... Bei der Abfassung seines Buches hat er offensichtlich jeden Zweifel, der [...]

Ein Leitfaden zur Datenauswertung in der digitalen Welt Das Buch „Data Analytics: Ein Leitfaden zur Datenauswertung in der digitalen Welt“ von Klaus-Dieter Sedlacek bietet eine [...]

„John Carter – Rückkehr zum Mars“ von Edgar S. Lorne ist ein spannendes Abenteuer, das die klassische John-Carter-Saga aufgreift und weiterführt. Das Buch zieht Leser [...]

Autor: Rutherford, Ernest. Das Verständnis des Aufbaus der Atome und der Atomkerne ist entscheidend, um die Welt verstehen. Mit einem besseren Verständnis der Kräfte in den Kernen und wie sie aufeinander wirken, können Forscher neue Technologien entwickeln, die uns helfen, unser Leben zu verbessern. Es kann uns beispielsweise ermöglichen, energiereichere [...]

Aus der Liste der 100 besten Romane des 20. Jahrhunderts. von Vicente Blasco Ibáñez. Die vier Reiter der Apokalypse (spanisch: Los cuatro jinetes del Apocalipsis) [...]

Praxisnah, kurz und prägnant. Autor: Sedlacek, Klaus-Dieter. Entdecken Sie „IT- und KI-Grundwissen für Einsteiger“ von Klaus-Dieter Sedlacek – das perfekte Buch, um in die Welt [...]

Neuübersetzung 2023. Autor: Poincaré, Henri. In „Wissenschaft und Hypothese (frz. La Science et l’Hypothèse)“ wird eine tiefgründige Analyse der Wissenschaft und ihrer Beziehung zu Hypothesen [...]

In „Wie wir denken“ präsentiert John Dewey tiefgründige Einblicke in die Natur des menschlichen Denkens und die Bildung des Geistes. Als führender Vertreter des Pragmatismus [...]

und das Kind und der Lehrplan. Autor: Dewey, John. Das Buch „Moralische Grundsätze in der Erziehung und das Kind und der Lehrplan“ erklärt Ihnen auf [...]

Entdecken Sie mit „Grenzüberschreitungen: Migration, Integration und die Herausforderungen unserer Zeit“ eine tiefgreifende und umfassende Analyse des aktuellen globalen Phänomens der Migration. Verfasst von renommiertem [...]

Die schwarzen Königreiche Zentralafrikas – I. Darfur und II. Wadai. Autor: Ibn Umar Tunisi, Muhammad. „Reisen eines arabischen Kaufmanns in den Sudan“ entführt die Leser [...]

„Nach dem Fall der Maschinen“ ist ein packender und tiefgründiger Science-Fiction-Roman, der weit über den üblichen Kampf zwischen Mensch und Maschine hinausgeht. Es ist nicht [...]

Programmieren mit ChatGPT Von Klaus-Dieter Sedlacek Tauchen Sie in die Zukunft der Java-Entwicklung ein mit „ChatGPT: Der Game-Changer für Java-Entwickler“! Dieses Buch enthüllt die Bedeutung [...]

Über die Idee des Fortschritts, die Entstehung und Entwicklung. Autor: Bury, J. B. „Zivilisation und Fortschritt: Über die Idee des Fortschritts, die Entstehung und Entwicklung [...]

Autor: Baden-Powell, Robert. Entdecken Sie die aufregende Welt der Spionage durch die Augen von Robert Baden-Powell, einem britischen General, Schriftsteller und Gründer der Pfadfinderbewegung. In [...]

Autor: Boole, George. Das Logik-Kalkül von Boole ist ein Formalismus, der von George Boole entwickelt wurde, um die Logik in algebraischer Form darzustellen. Mit diesem Formalismus können Aussagenlogik und Wahrscheinlichkeitstheorie mathematisch analysiert werden. Boole'sche Algebra (auch als Boolean Algebra bezeichnet) ist die Grundlage für viele Bereiche der modernen Mathematik und [...]

Eine Einführung in das Studium des Menschen und der Zivilisation In „Anthropology: Eine Einführung in die Erforschung des Menschen und der Zivilisation“ entführt Edward B. [...]

Das Buch Der Preis politischer Ideale von Alex Goodman untersucht, wie idealistische politische Konzepte mit den wirtschaftlichen Realitäten der modernen Welt kollidieren. Die zentrale Thematik [...]

Erklärungen, Theorien und Lehrmeinungen. Autor: Flammarion, Camille. Dieses faszinierende Werk, verfasst von Camille Flammarion, einem talentierten und anerkannten Astronomen, stellt ein umstrittenes Thema dar, den [...]

Über die Idee des Fortschritts, die Entstehung und Entwicklung. Autor: Bury, J. B. „Zivilisation und Fortschritt: Über die Idee des Fortschritts, die Entstehung und Entwicklung [...]

Natürliche Grundlagen einer Theorie des evolutiven Quantenbewusstseins. Autoren: Wrobel, Norbert; Sedlacek, Klaus-Dieter. Seltsam sind die physikalischen Gesetze, die unsere Welt wirklich beherrschen: Es sind die Gesetze einer makroskopischen Quantenwelt, in [...]

Geschichte der Chemie. Autor: Ostwald, Wilhelm. Der visionäre Nobelpreisträger Wilhelm Ostwald, der den Übergang zur modernen wissenschaftlichen Chemie mitgestaltete, erzählt die aufregende Entwicklung seines Fachbereichs. Das Buch schließt mit einem [...]

Programmieren mit ChatGPT Von Klaus-Dieter Sedlacek Tauchen Sie in die Zukunft der Java-Entwicklung ein mit „ChatGPT: Der Game-Changer für Java-Entwickler“! Dieses Buch enthüllt die Bedeutung [...]

Die Top10-Physiker der Menschheitsgeschichte. Hrsg.: Sedlacek, Klaus-Dieter (Hrsg.). Den meisten Menschen sind Schöpfer von Kunst und Literatur vertraut, sie kennen unsere Staatslenker und Wirtschaftsführer, doch wer kennt die Giganten der [...]

Historische Erzählung. Autor: Colerus, Egmont. Die historische Erzählung handelt davon, wie vor 2200 Jahren der geniale Mathematiker und Mechaniker Archimedes die nach ihm benannte Spirale erfand. Eine ägyptische Muse, zu [...]

Und ihre Anwendungen - Eine Theorie des Überlebensmechanismus. Autor: Carington, Walter Whately. Whately Carrington, ein prominenter Erforscher des Paranormalen aus dem frühen 20. Jahrhundert nimmt sich seltsamer und wunderbarer Themen [...]

Komet und Weltuntergang: Die Gefahr aus dem All. Autor: Bölsche, Wilhel. Als 2006 der erdbahnkreuzende Komet 73P/Schwassmann-Wachmann 3 in einige Stücke zerbrach, war dies der Bild-Zeitung einen schaurigen Bericht unter [...]

Autor: Driesch, Hans. Mit den »mystischen«, »irrationalen« Neigungen hat die Parapsychologie gar nichts zu tun. Sie ist Wissenschaft, ganz ebenso, wie Chemie und Geologie Wissenschaften sind. Unmittelbar »schauen« tut sie [...]

Wie Enzyme, Bewusstsein und quantenbiologische Effekte das Leben regulieren. Autoren: Sedlacek, Klaus-Dieter; Wrobel, Norbert. Der Begründer der Quantenmechanik und Nobelpreisträger Erwin Schrödinger beschäftigte sich unter anderem mit der Frage: "Was [...]

Materialisations-Experimente mit M. Franek-Kluski. Autor*innen: Sedlacek, Klaus-Dieter; Schrenck-Notzing, A. Freiherrn von. Die vorliegende Schrift beschäftigt sich mit speziellen physikalischen Phänomenen, nämlich der durch Versuchspersonen verursachten Materialisation von Objekten. Das tatsächliche [...]

Autor: Hensel, Kurt. Als die Aufgabe der elementaren Zahlentheorie kann die Aufsuchung der Beziehungen bezeichnet werden, welche zwischen allen rationalen ganzen oder gebrochenen Zahlen m einerseits und einer beliebig angenommenen [...]

Elementare Information und reiner Zufall im Nichts als Bausteine einer 4-dimensionalen Quanten-Welt. Autoren: Wrobel, Norbert; Sedlacek, Klaus-Dieter. Obwohl bereits vor mehr als hundert Jahren die Quantenphysik Gestalt annahm, setzte sich [...]

Eine vergleichende experimentelle Untersuchung über die Entstehung von Technik und Kunst. Autor: Dennert, Eberhard. Die Erforschung des Urmenschen hat in den letzten Jahrzehnten einen ganz ungeahnten Aufschwung genommen und zwar [...]

Die unmittelbaren Gegebenheiten des Bewusstseins. Autor: Bergson, Henri. Zeit und Willensfreiheit: Ein Essay über die unmittelbaren Gegebenheiten des Bewusstseins (französisch: Essai sur les données immédiates de la conscience) ist Henri [...]

Eine populäre Erläuterung der berühmten Theorie (Neuübersetzung). Autor: Nordmann, Charles. Einsteins Theorien haben eine tiefgreifende Revolution in der Wissenschaft herbeigeführt. In ihrem Licht erscheint die Welt einfacher, koordinierter, einheitlicher. Wir [...]

Das psychische Leben von Mikroorganismen - Eine Studie in experimenteller Psychologie. Autor: Binet, Alfred. Es gibt mikroskopisch winzige Lebewesen, die kein Gehirn haben und dennoch so etwas wie ein Gedächtnis. [...]

Autor: Boole, George. Das Logik-Kalkül von Boole ist ein Formalismus, der von George Boole entwickelt wurde, um die Logik in algebraischer Form darzustellen. Mit diesem Formalismus können Aussagenlogik und Wahrscheinlichkeitstheorie [...]

Das Gesetz im Zufall. Autor: Cantor, Moritz. Zufall wurde es Jahrhunderte lang genannt, wenn der Wind von Süd nach Südwest, von Nord nach Nordost umzuschlagen pflegte und nicht etwa die [...]

Praxisnah, kurz und prägnant. Autor: Sedlacek, Klaus-Dieter. Entdecken Sie „IT- und KI-Grundwissen für Einsteiger“ von Klaus-Dieter Sedlacek – das perfekte Buch, um in die Welt [...]

Sechs Vorträge. Autor: Schleich, Carl Ludwig. Schleich gibt in diesem Werk als Erster eine physiologische Darstellung der Vorgänge, welche zu einem Ichgefühl führen. Ihm steht als erfahrener Mediziner das Experiment [...]

Die Tarner-Vorlesungen gehalten am Trinity College. Autor: Whitehead, Alfred North. Alfred North Whiteheads „Das Wesen der Natur“ revolutioniert das Denken über den Umgang der Naturwissenschaften [...]

und wie der Zufall zu Entdeckungen führt. Autor: Cantor, Moritz. Was ist denn der Zufall? Ist der Eintritt eines Ereignisses Zufall, wenn es genauso gut auch hätte ausbleiben können? Und [...]

Geschichte der Chemie. Autor: Ostwald, Wilhelm. Einführend berichtet Justus Liebig, wie die voller Geheimnisse steckende Alchemie die Grundlagen der heutigen Chemie geschaffen hat. Der visionäre Nobelpreisträger Wilhelm Ostwald, der den [...]

Neue Erkenntnisse über die Gestalten biotechnischer Systeme der Welt. Autor: Francé, Raoul H. Seit Jahrtausenden ist die Menschheit bestrebt, die Welt, in der sie lebt, erkennen und verstehen zu lernen. [...]

4000 Jahre Pionier-Arbeit. Autor: Darmstaedter, Ludwig. Die Chronologie der Exakten Wissenschaften umfasst die Entwicklung der empirischen und systematischen Erforschung der Natur von der Frühgeschichte bis zum Wechsel ins zwanzigste Jahrhundert. [...]

Wahrscheinlichkeiten abschätzen. Autor*innen: Sedlacek, Klaus-Dieter (Hrsg.) Dieses Buch hilft, Wahrscheinlichkeiten besser beurteilen zu können. Zum Inhalt: - Wie einfache Überlegungen zu den Grundprinzipien von Vorhersagen führen - Die Klassenlotterie - [...]

Das Geheimnis hinter den Erscheinungen der Welt. Autor: Sedlacek, Klaus-Dieter (Hrsg.). Was uns an den beinahe mythischen Denkern der antiken Welt so fasziniert, ist die wundervolle, abgeschlossene Einheit ihres Weltbildes. [...]

Neuübersetzung 2023. Autor: Poincaré, Henri. In „Wissenschaft und Hypothese (frz. La Science et l’Hypothèse)“ wird eine tiefgründige Analyse der Wissenschaft und ihrer Beziehung zu Hypothesen [...]

In welcher Form existiert ein Weiterleben nach dem zeitlichen Ende? Autor*innen: Ostwald, Wilhelm. Das hier veröffentlichte Buch ist die deutsche Übersetzung eines Vortrages, den der Nobelpreisträger Wilhelm Ostwald an der [...]

Das Wesen der Naturgesetze. Autor: Schlick, Moritz. Die Naturphilosophie verhält sich zur Naturwissenschaft wie die Philosophie im Allgemeinen zur Wissenschaft überhaupt. So ist es die Aufgabe der Naturphilosophie, für das [...]

Die elegante Frau vom 18. bis ins 20. Jahrhundert. Autorin: Aretz, Gertrude. Die Kunst und die Lust zu gefallen, anzuziehen und mit besonderer Betonung aller Reize zu verführen, sind in [...]

Aufgedeckte Naturgeheimnisse. Autor: Laßwitz, Kurd. In diesem Buch nimmt der Autor Stellung zu Fragen folgender Art: Lässt uns die Natur in ihre Werkstatt blicken? Wie hängen Bewusstsein und Natur zusammen? [...]

und Naturwissenschaft. Autoren: Sedlacek, Klaus-Dieter; Schlick, Moritz. Es die Aufgabe der Naturphilosophie, für das Gebiet der naturwissenschaftlichen Erkenntnis einen wesentlichen Beitrag zu leisten. Es sind jene Fragen, die auf die [...]

Autor: Markoff, A. A. In diesem Buch entwickelt der Autor die Wahrscheinlichkeitsrechnung als eine mathematische Disziplin, ohne sich mit ausführlicher Betrachtung ihrer mehr oder weniger wichtigen Anwendungen zu befassen. Ohne [...]

Mathematik für Jedermann. Autor: Colerus, Egmont Colerus nimmt die dankenswerte, aber auch schwierige Aufgabe auf sich, Freunde und Feinde der Mathematik zu versöhnen. Es gibt eine große Anzahl Menschen, die [...]

Eine kurze und prägnante Einführung. Autor: Kirchberger, Dr. Paul. Form und Inhalt des vorliegenden Bändchens bestimmen sich dadurch, das es eine in sich abgerundete und verständliche Darstellung seines Gegenstandes sein [...]

Fantastische Einblicke in andere Welten. Autor: Proctor, Richard A. Die Mythen und Wunder der Astronomie sind eine faszinierende Kraft, die uns in unergründliche Welten eintauchen lässt. Dieses Buch befasst sich [...]

mit einer Einführung von PROF. W. F. BARRETT, F.R.S. Ehemaliger Präsident der Gesellschaft für Psychische Forschung. Autor: Willson, Beckles. Als der Autor sich zum ersten Mal in das weite und [...]

In Neusatz und aktueller Rechtschreibung. Autor: du Prel, Carl. Der Spiritismus ist ohne Zweifel die paradoxeste aller Wissenschaften und er wird es wohl noch lange bleiben. Das liegt offenbar nur [...]

Einführung in die Erkenntnistheorie. Autor: Becher, Erich. Die Erkenntnistheorie ist als besonderes Gebiet der Philosophie die philosophische Grundwissenschaft, die aller Spekulation und aller Wissenschaft vorangehen muss. Diese Einführung hilft dabei, [...]

Autor: Rutherford, Ernest. Das Verständnis des Aufbaus der Atome und der Atomkerne ist entscheidend, um die Welt verstehen. Mit einem besseren Verständnis der Kräfte in den Kernen und wie sie [...]

Der Zusammenhang zwischen Physis und Psyche. Autor: Valier, Max. In dem Buch "Das transzendentale Gesicht der Welt" geht es um eine bisher unbekannte Wellengattung, die psychophysische Welle, welche eine Verbindung [...]

und Früchte vom Baum der Erkenntnis Autor: Bölsche, Wilhelm Wir sind dem wahren Geheimnis der Menschwerdung noch nie so nahe gewesen, als der Psychologe Wolfgang Köhler in dem kleinen Schimpansenparadies [...]

Space-time Phenomena Evidence And Visions. Author: Sedlacek, Klaus-Dieter. Thirty-five top-class scientists have a vision. They meet in seclusion and want to learn about the immortality of consciousness and the meaning [...]

Leben wir im Innern einer Kugel? Autor: Ives, F. T. In dieser einfachen gemeinverständlichen Abhandlung werden einige von Wissenschaftlern aufgestellte Theorien überprüft und kritisiert sowie einige neue Theorien vorgestellt werden, [...]

Geschichte der Mathematik für jedermann. Autor: Colerus, Egmont. Colerus ist der berufene Autor, der die Epochen der Mathematik darzustellen vermag. Nur er hat die Gabe, wissenschaftliche Dinge so darzustellen, dass [...]

Wasserstoff, Solarzellen und Kernfusion - Pressemeldungen zum Stand der Forschung. Hrsg.: Sedlacek, Klaus-Dieter (Hrsg.). Wie sieht die Energie der Zukunft aus nach dem Ende fossiler Energien? Wie weit ist die [...]

Roboter im Krisenmodus: Wirtschaftsanalyst:innen untersuchen industrielle Auf- und Abschwünge. Während viele Unternehmen in der Rezession Personalkosten drücken, steigt gleichzeitig die Bereitschaft, in Automatisierung zu investieren — nicht aus Luxus, sondern [...]

"Neue Technologien als Schlüssel für Standortvorteile: Einfluss auf die Wirtschaftspolitik im Fokus einer Benchmarkstudie." Wussten Sie, dass Unternehmen, die innovative Technologien nicht nur anwenden, sondern auch aktiv in ihre Geschäftsstrategien [...]

Deutschland im Fokus: Neu bewertete Ansätze für eine zukunftssichere Wirtschaftsförderung. Deutschland ist nicht nur ein Industriezentrum – es ist ein strategischer Knotenpunkt, dessen Vorteile sich oft unterschätzt werden: zentrale Lage [...]

„Europa braucht digitale Unabhängigkeit für erfolgreiche Industriekonferenzen" Europa steht vor der Herausforderung, seine digitale Infrastruktur grundlegend zu modernisieren und auszubauen, um mit globalen Wettbewerbern Schritt halten zu können. Der Rückstand, [...]

Wirtschaft im Wandel: Industrieausschüsse ebnen den Weg für die Zukunft der Fertigung. Digitale Transformation heißt nicht nur neue Maschinen — sie verändert, wer entscheidet, wie Arbeit organisiert wird und welche [...]

"Mobilitätswende im Mittelstand: Chancen und Herausforderungen für Unternehmen im Zukunftsplan" In den kommenden Jahren wird die Mobilitätswende nicht nur unsere Straßen, sondern auch die DNA des Mittelstands fundamental verändern. Die [...]

"Roboter im Büro: Neue Arbeitsbeziehungen im New-Work-Zeitalter" Bis 2030 werden kollaborative Roboter in vielen Produktions- und Dienstleistungsumgebungen alltäglicher sein als Praktikanten — nicht, weil sie Menschen ersetzen, sondern weil sie [...]

Industrie im digitalen Wandel: Chancen nutzen und die digitale Kluft überwinden. Erstaunlich: In vielen Produktionshallen begegnet man auf engstem Raum modernster Automatisierungstechnik und gleichzeitig unverändertem Papierkram — ein sichtbares Zeichen [...]

Roboter made in Europe – Technologische Souveränität im Technologiediskussion Wussten Sie, dass Europa in der Robotik nicht nur ein wichtiger Akteur, sondern auch ein Hotspot für technologische Innovationen ist? Inmitten [...]

"Europas Fabriken: Strategien für die Rückkehr zur Produktion vorgestellt" Ein einziges fehlendes Bauteil kann binnen Stunden eine gesamte Produktionslinie zum Stillstand bringen — und trotzdem setzen viele Betriebe weiterhin auf [...]

Daten statt Diesel – Wenn Mobilität zur Plattform wird als Erklärfilm Wussten Sie, dass bis zu 90% der Verkehrsdaten ungenutzt bleiben? In der heutigen Zeit, wo Daten als das neue [...]

"Zahlen als neue Ressource: Entscheidungsfinder:innen optimieren Märkte durch datengestützte Erkenntnisse." Daten schaffen Märkte — und zwar schnell, lautlos und oft an Orten, an denen niemand zuvor Handel vermutet hätte: von [...]

Technologischer Wandel: Deindustrialisierung oder Chancen für die Industrie? Maschinen denken mit — die Fabrikhalle von morgen ist keine Ansammlung starrer Fließbänder mehr, sondern ein lernendes, vernetztes Ökosystem, das Produktion neu [...]

"Europa entwickelt neue Strategien für Digitalstrateg:innen zur Reduzierung von Abhängigkeiten." Die Abhängigkeit von digitalen Plattformen und Technologien hat mittlerweile ein Ausmaß erreicht, das nicht nur Unternehmen, sondern auch ganze Gesellschaften [...]

Maschinenlernen revolutioniert Produktion: Neue Ansätze für die Automatisierungstrategie. In vielen Fertigungsstraßen entscheidet heute eine KI binnen Sekundenbruchteilen, ob ein Bauteil in den Ausschuss wandert oder weiterverarbeitet wird — und das [...]

"Von der Simulation zur Realität: Produktentwicklung effizient gestalten." Simulation ist nicht länger ein optionales Werkzeug — sie entscheidet schon früh im Entwicklungsprozess über Zeitplan, Qualität und Marktakzeptanz eines Produkts. Um [...]

Mobilitätswandel lokal: Transformative Diskussionen zur Zukunft des Verkehrs in unserer Region. Fast 80 % aller Wege in ländlichen Regionen beginnen und enden mit dem Auto — ein Spiegelbild tief verwurzelter [...]

Digital first, Arbeitsplatz second? – Was bleibt vom Beruf? für Arbeitsmarktforscher:innen Wussten Sie, dass bis zu 85% der Jobs in den nächsten 10 Jahren durch digitale Technologien transformiert oder sogar [...]

"Big Data verstehen: Die Schlüsselressource für erfolgreiches Geschäft" Ein einziger Klick, eine Sensorablesung oder ein abgeschlossener Einkauf — in ihrer Summe verwandeln sich scheinbar banale digitale Spuren in eine der [...]

"Technologie und Ungleichheit: Wer wird im digitalen Zeitalter übersehen?" Mehrere Milliarden Menschen sind von der digitalen Welt ausgeschlossen – und das bedeutet nicht nur fehlendes Internet, sondern verlorene Chancen auf [...]

"Virtuelle Technik revolutioniert Märkte: Einfluss der Simulation auf das Management" Ein einziger Rechenlauf kann heute Märkte umkrempeln: Simulationen erlauben es, komplexe Entscheidungen in Sekunden zu testen, die früher Monate an [...]

Disruption für alle: Wer profitiert und wer bleibt auf der Strecke? Disruption schafft nicht automatisch gerechten Fortschritt; sie wirkt oft wie ein Vergrößerungsglas für bestehende Ungleichheiten und beschleunigt Prozesse, die [...]

Technologischer Fortschritt: Schlüssel zu wirtschaftlichem Wandel und nachhaltigem Wohlstand. Technologischer Fortschritt ist kein sanfter Motor – er ist ein Beschleuniger, der Produktivität, Märkte und Lebensweisen innerhalb weniger Jahre verändert. Wirtschaftliches [...]

Digitalisierung ohne Plan – Digitalisierung als Strohfeuer? für Entscheider:innen Ohne klare Strategie verpufft Digitalisierung schnell als teures Strohfeuer — nachhaltige Transformation entsteht nicht durch Zufall, sondern durch ein konsequentes Zusammenspiel [...]

"Zwei Geschwindigkeiten: Warum einige Unternehmen im Wettbewerb zurückfallen" Nicht die beste Technologie entscheidet, sondern wer das Tempo hält: Unterschiedliche Branchen und Unternehmen laufen mit ungleichen Gesetzen — und das erklärt, [...]
25. Juni 2026
 Mindelo (São Vicente). Seit fünf Jahre leuchtet nachts ein markanter grüner Laserstrahl bis zu 30km über dem Hafen der Inselhauptstadt. Er gehört zu einem Hochenergie-Lidar mit dem am Ocean Science… Weiterlesen …
Mindelo (São Vicente). Seit fünf Jahre leuchtet nachts ein markanter grüner Laserstrahl bis zu 30km über dem Hafen der Inselhauptstadt. Er gehört zu einem Hochenergie-Lidar mit dem am Ocean Science… Weiterlesen …
25. Juni 2026
 Eine Studie des Potsdam-Instituts für Klimafolgenforschung (PIK) beleuchtet jetzt erstmals für einen Großteil der Welt die CO₂-Intensität des Konsums privater Haushalte – und damit die Verteilungswirkung von Klimapolitik, die ja… Weiterlesen …
Eine Studie des Potsdam-Instituts für Klimafolgenforschung (PIK) beleuchtet jetzt erstmals für einen Großteil der Welt die CO₂-Intensität des Konsums privater Haushalte – und damit die Verteilungswirkung von Klimapolitik, die ja… Weiterlesen …
24. Juni 2026
 Das JUNO-Experiment im Süden Chinas vermisst die Energie der Geisterteilchen äußerst präzise. Wellenförmige Strukturen im Spektrum liefern Hinweise auf die Masse der Neutrinos. Quelle: FAZ.de
Das JUNO-Experiment im Süden Chinas vermisst die Energie der Geisterteilchen äußerst präzise. Wellenförmige Strukturen im Spektrum liefern Hinweise auf die Masse der Neutrinos. Quelle: FAZ.de
25. Juni 2026

25. Juni 2026
 Das neue SC-Mercator CAT.6a highflex Patchkabel meistere durch seinen äußerst geringen Außendurchmesser von nur 6 mm sowie einen kleinen Biegeradius von weniger als 20 mm problemlos enge Patchfelder, Datenschränke oder… Weiterlesen …
Das neue SC-Mercator CAT.6a highflex Patchkabel meistere durch seinen äußerst geringen Außendurchmesser von nur 6 mm sowie einen kleinen Biegeradius von weniger als 20 mm problemlos enge Patchfelder, Datenschränke oder… Weiterlesen …
25. Juni 2026
 K-array hat auf der InfoComm 2026 zwei neue Produkte vorgestellt: den ultraflachen Architektur-Subwoofer Keystone KST110 und den ultrakompakten Punktschallquellen-Lautsprecher Dragon KX2. Beide Modelle richten sich an Installationen, bei denen Audioleistung… Weiterlesen …
K-array hat auf der InfoComm 2026 zwei neue Produkte vorgestellt: den ultraflachen Architektur-Subwoofer Keystone KST110 und den ultrakompakten Punktschallquellen-Lautsprecher Dragon KX2. Beide Modelle richten sich an Installationen, bei denen Audioleistung… Weiterlesen …
Umwelt-DNA macht globale Veränderungen der Fischvielfalt sichtbar
25. Juni 2026
Eine weltweite Analyse der Artenvielfalt von Fischen anhand von Umwelt-DNA (eDNA) zeigt, wie Mensch und Klima die Biodiversität in Flussökosystemen beeinflussen. Während in warmen Klimazonen die Artenvielfalt in grossen Flusseinzugsgebieten… Weiterlesen …
Roboter made in Europe – Technologische Souveränität im Technologiediskussion
21. Juni 2026
Roboter made in Europe – Technologische Souveränität im Technologiediskussion Wussten Sie, dass Europa in der Robotik nicht nur ein wichtiger Akteur, sondern auch ein Hotspot für technologische Innovationen ist? Inmitten… Weiterlesen …
Gesetzesentwurf der EU-Kommission zu Pestiziden: Europäische Forscher*innen benennen Risiken
20. Juni 2026
Die Europäische Kommission will zentrale Bestimmungen, die bisher für die Zulassung von Pestiziden gelten, mit einem neuen Gesetzespaket reformieren. Wissenschaftler*innen von 27 europäischen Forschungseinrichtungen weisen darauf hin, dass das „Omnibus-Paket… Weiterlesen …
Supermärkte treiben Nachhaltigkeit voran – könnten aber ambitionierter sein
20. Juni 2026
„Sind Supermärkte Treiber der Nachhaltigkeitstransformation?“ Neue Forschungsergebnisse des IDOS sowie universitärer Partnerinstitutionen aus Schweden, der Türkei und den USA zeigen: Lebensmitteleinzelhändler treiben Umwelt- und Klimaschutzmaßnahmen oftmals erfolgreich voran. Quelle: IDW… Weiterlesen …
Führungswechsel bei d&b: Performance Audio mit Haltung
18. Juni 2026
Von der kleinen Manufaktur im schwäbischen Hinterland zu einem globalen Player: Die d&b audiotechnik hat in den Jahrzehnten ihres Bestehens einige Firmen- und Organisationsstrukturen durchlaufen. Nach dem ersten Einstieg von… Weiterlesen …
Wie wird man klein? Neue Studie enthüllt unterschiedliche Wachstumsstrategien bei Dimetrodon
17. Juni 2026
Der ikonische Segelrückenräuber Dimetrodon gilt als eines der bekanntesten Tiere des frühen Perms – lange bevor Dinosaurier die Erde dominierten. Die meisten bekannten Arten dieses frühen Verwandten der Säugetiere erreichten… Weiterlesen …
Digital first, Arbeitsplatz second? – Was bleibt vom Beruf? für Arbeitsmarktforscher:innen
16. Juni 2026
Digital first, Arbeitsplatz second? – Was bleibt vom Beruf? für Arbeitsmarktforscher:innen Wussten Sie, dass bis zu 85% der Jobs in den nächsten 10 Jahren durch digitale Technologien transformiert oder sogar… Weiterlesen …
Wal »Timmy«: Museen buhlen um Buckelwal-Überreste
15. Juni 2026
Flosse, Beckenknochen und Rückenwirbel? Gesichert! Einige Knochen des als »Timmy« bekannten Buckelwals sollen Ausstellungsstücke werden. Museumsbesucher sollen sich fragen: »Wie gehen wir mit der Natur um?« Quelle: SPIEGEL ONLINE Wissenschaft
Mykorrhiza-Netzwerke: Wie Pilze unterirdisch unsere ganze Welt umspannen
13. Juni 2026
Mykorrhiza-Pilze setzen sich auf Pflanzenwurzeln und breiten sich so immer weiter aus. Ihre Netzwerke sind so dicht und lang, dass man damit 750 Mal von der Erde zur Sonne käme.… Weiterlesen …
Relevanz und Handlungsbereitschaft zu Umweltschutz weiterhin auf hohem Niveau
12. Juni 2026
Wie nehmen Bürgerinnen und Bürger ökologische Herausforderungen wahr? Und wie aktiv sind sie selbst in Sachen Umweltschutz? Diesen Fragen geht das Fraunhofer-Institut für Umwelt-, Sicherheits- und Energietechnik UMSICHT in sich… Weiterlesen …
Umwelt-DNA macht globale Veränderungen der Fischvielfalt sichtbar
Published on 25. Juni 2026
Eine weltweite Analyse der Artenvielfalt von Fischen anhand von Umwelt-DNA (eDNA) zeigt, wie Mensch und Klima die Biodiversität in Flussökosystemen beeinflussen. Während in warmen Klimazonen die Artenvielfalt in grossen Flusseinzugsgebieten… Weiterlesen …
Was früher eine Jahrhundert-Sturmflut war, tritt heute alle acht Jahre auf
Published on 11. Juni 2026
Sturmfluten und andere extreme Wasserstände an Küsten sind heute deutlich wahrscheinlicher als noch im Jahr 1900. Eine neue Studie in Nature Climate Change zeigt: Was damals ein Jahrhundertereignis war, tritt… Weiterlesen …
Europa profitiert von einer schnelleren Energiewende
Published on 2. Juni 2026
Aufgrund steigender und volatiler Preise fossiler Energieträger ist zu erwarten, dass ein beschleunigter Ausbau erneuerbarer Energieformen nicht nur dem Klima zugutekommt, sondern auch erhebliche Zusatznutzen für Luftqualität, Gesundheit und Wirtschaft… Weiterlesen …
Wie Europas Landschaften Klima und Biodiversität gleichzeitig schützen können
Published on 23. Mai 2026
Ein neues Konzept zeigt, wie europäische Regionen auf unterschiedliche, sich gegenseitig ergänzende Weise zu Klima- und Naturschutzzielen beitragen können. Quelle: IDW Informationsdienst Wissenschaft
Digitale Zwillinge als ProAV-Booster
Published on 14. Mai 2026
Digitale Zwillinge eröffnen Unternehmen neue Dimensionen bei Planung, Kontrolle und Optimierung audiovisueller Installationen. Als virtuelle Repräsentationen von Produkten, Prozessen oder Orten verknüpfen sie Medientechnik, Gebäudedaten und Sensorik zu einem Echtzeitabbildbilden.… Weiterlesen …
Klima: El Niño erhöht das Risiko für bewaffnete Auseinandersetzungen
Published on 13. Mai 2026
Trockene El-Niño-Jahre können laut Forschern bewaffnete Konflikte fördern. Doch Klima allein erklärt keine Kriege. Quelle: SZ.de
Published on 12. Mai 2026
Der überregionale und interdisziplinäre Forschungsverbund „Klima-Anpassung, Hochwasser, Resilienz“ (KAHR) hat bereits wichtige Anstöße für einen nachhaltigen und resilienten Wiederaufbau nach dem Hochwasser im Ahrtal und in Nordrhein-Westfalen gegeben. In der… Weiterlesen …
Binnenmeere weltweit sind stark vom Klimawandel betroffen
Published on 12. Mai 2026
Unter Leitung des Leibniz-Instituts für Ostseeforschung Warnemünde (IOW) wurde erstmals mit Klimasimulationen untersucht, wie 19 Binnenmeere, auch die Ostsee, auf den Klimawandel reagieren. Die Forschenden fanden heraus, dass die Meere… Weiterlesen …
Pflanzenstress: Signalnetzwerke mal anders
Published on 9. Mai 2026
Das Molekül cAMP, das in tierischen Zellen essenzielle Funktionen erfüllt, ist in Pflanzen deutlich weniger erforscht. In einer neuen Studie in Science Advances zeigen Wissenschafter:innen am Institute of Science and… Weiterlesen …
3-in-1-Touchpanel für Gebäude- und Raumsteuerung
Published on 8. Mai 2026
Der Value Added Distributor Concept International hat die Qbic-Luminen-Pro-Serie vorgestellt – Touchpanel-PCs, die Touchscreen, Gateway mit I/O-Ports und Miniserver in einem Gerät vereinen. Die Panels sind für die Steuerung von… Weiterlesen …
Viren unter Stress: Wie Virushüllen sich beim Austrocknen verformen
25. Juni 2026
Wenn Viren in winzigen Tröpfchen durch die Luft transportiert werden, können sie schnell austrocknen. Dennoch bleiben viele Viren nach ihrer Rehydrierung infektiös – ein Phänomen, das noch nicht vollständig verstanden… Read more…
Studie zu moderatem Konsum: Wann wird Alkohol gefährlich?
24. Juni 2026
Forscher warnen, die Lobby bremst: In den USA wird über die Leitlinie zum Alkoholkonsum debattiert. Neue Auswertungen zeigen, wann Alkohol der Gesundheit schadet. Quelle: FAZ.de
Wie eine Mondrakete «en miniature»: Forschende entwickeln modularen Nanoroboter
18. Juni 2026
Ein Team der Universität Basel hat einen vielseitigen Nanoroboter mit Antriebs- und Nutzlastmodul entwickelt. Die beiden wiederverwendbaren Module fügen sich selbstständig zusammen und könnten in der Medizin oder der Industrie… Read more…
Windräder verursachen keine nachweisbaren Gesundheitsschäden
17. Juni 2026
Umfangreiche, über 12 Jahre währende Längsschnittuntersuchung rund um Wohnnähe zu Windrädern und Gesundheit in renommierter Fachzeitschrift PNAS zeigz: Wohnnähe zu Windrädern ist in den untersuchten US-Daten nicht mit Schlafstörungen, Depressionen,… Read more…
17. Juni 2026
Forschungsprojekt »NEMO«: Anonymisierungsverfahren für EEG-Signale entwickelt Die Aufzeichnung der Hirnaktivität über Elektroenzephalogramme (EEG) liefert in der Wissenschaft und Medizin wichtige Erkenntnisse. Die individuellen Datenmuster ermöglichen aber auch Rückschlüsse auf einzelne… Read more…
Digital first, Arbeitsplatz second? – Was bleibt vom Beruf? für Arbeitsmarktforscher:innen
16. Juni 2026
Digital first, Arbeitsplatz second? – Was bleibt vom Beruf? für Arbeitsmarktforscher:innen Wussten Sie, dass bis zu 85% der Jobs in den nächsten 10 Jahren durch digitale Technologien transformiert oder sogar… Read more…
Hitzeaktionstag: Wie sich Hitzewellen auf unseren Körper auswirken
9. Juni 2026
Am 11. Juni findet der Deutsche Hitzeaktionstag statt, um auf die Risiken aufmerksam zu machen, die die klimawandelbedingt steigenden Temperaturen verursachen. Viele davon betreffen die menschliche Gesundheit. Wie sich Hitzetage… Read more…
Ebola-Ausbruch in Afrika: Internationale Geldgeber investieren Millionen in Impfstoffe
3. Juni 2026
Die Zahl der Ebolainfizierten in Zentralafrika wächst. Im Kampf gegen die tödliche Krankheit bekommen Firmen und Forscher nun Finanzhilfen, ein großer Betrag geht an den US-Hersteller Moderna. Quelle: SPIEGEL ONLINE… Read more…
Pestizidzulassung: Bürokratieabbau auf Kosten der Gesundheit?
2. Juni 2026
Die EU-Kommission plant, die Regulierung von Pflanzenschutzmitteln zu vereinfachen. Doch Wissenschaftler warnen, die Pläne würden Umwelt und Gesundheit gefährden. Quelle: SZ.de
Europa profitiert von einer schnelleren Energiewende
2. Juni 2026
Aufgrund steigender und volatiler Preise fossiler Energieträger ist zu erwarten, dass ein beschleunigter Ausbau erneuerbarer Energieformen nicht nur dem Klima zugutekommt, sondern auch erhebliche Zusatznutzen für Luftqualität, Gesundheit und Wirtschaft… Read more…
mRNA-Arzneimittel für mehr Menschen verfügbar machen
2. Juni 2026
Innovative Therapeutika und Impfstoffe auf mRNA-Basis gelten als Hoffnungsträger gegen Krebs, Erbkrankheiten oder Infektionen. Doch ihre Entwicklung und Herstellung ist aufwendig, langsam und kaum skalierbar. Sieben Fraunhofer-Institute haben beschlossen, das… Read more…
Lebende Arzneimittel: Bioreaktor in der Blutbahn
31. Mai 2026
Die Medikamente der nächsten Generation leben und agieren selbstständig im Körper, nachdem sie trickreich programmiert wurden. Allerdings ist die Einführung der neuen Medizin noch hindernisreich. Quelle: FAZ.de
Podcast „Auf den Punkt“: Wie Frauen in der Medizin übersehen werden
29. Mai 2026
Krankheiten, die nur Frauen betreffen, sind weniger erforscht. Über die Kluft zwischen den Geschlechtern auch in der Medizin. Quelle: SZ.de
Esa-Weltraumteleskop »Euclid« zeigt helles Zentrum der Milchstraße
25. Juni 2026
Die Aufnahme des Weltraumteleskops »Euclid« ist eine der detailliertesten vom inneren Bereich unserer Galaxie. Das Bild soll helfen, die Existenz von Planeten in fremden Sonnensystemen zu bestätigen. Quelle: SPIEGEL ONLINE… Weiterlesen …
Ukraine-Krieg: Russlands Militär pirschte sich an westlichen Radarsatelliten heran
25. Juni 2026
Gleich vier russische Satelliten haben sich einem finnischen Radarsatelliten genähert, der wohl auch von der Ukraine genutzt wird. Das Ziel könnte Einschüchterung gewesen sein – oder ein Waffentest im All.… Weiterlesen …
Abdul Ahad Momand: Er war der erste Afghane im All
24. Juni 2026
Abdul Ahad Momand flog 1988 als erster Afghane ins All – mit einer Flagge, zwei Koranausgaben und der Bitte um Frieden. Sein Land hörte nicht zu. Nun ist er in… Weiterlesen …
Artemis-Programm: Esa-Chef Aschbacher will europäische Astronauten auf dem Mond
16. Juni 2026
Er versprach einen Deutschen auf Mondmission, nun fliegt ein Italiener: Hier spricht Esa-Chef Josef Aschbacher über geplatzte Pläne und neue Verhandlungen. Und erklärt, warum Europa mehr sein will als Juniorpartner… Weiterlesen …
Artemis 3: Das ist die Crew für die nächste Mission des Mondprogramms
10. Juni 2026
Die nächste Mission des Nasa-Mondprogramms geht gar nicht zum Mond, ist aber trotzdem wichtig. Jetzt steht die Crew von Artemis 3 fest: drei Amerikaner und ein Italiener. Sie sollen 2027… Weiterlesen …
»James Webb«-Teleskop: Forscher wiegen inaktives schwarzes Loch
10. Juni 2026
Inaktive schwarze Löcher sind schwer aufzuspüren. Mit dem »James Webb«-Teleskop haben Forscher nun erstmals eines aus der Frühzeit gefunden. Möglich war das auch dank Albert Einstein. Quelle: SPIEGEL ONLINE Wissenschaft
Nasa: Diese Prada-Unterwäsche sollen Astronauten auf Mondmission tragen
9. Juni 2026
Die Luxusmarke Prada hat für die US-Raumfahrtbehörde Unterwäsche mit Schläuchen entwickelt. Sie soll bei der Mondmission drei wichtige Aufgaben erfüllen – PR und Imagepflege nicht eingerechnet. Quelle: SPIEGEL ONLINE Wissenschaft
Nasa: Mars-Orbiter »Maven« ist nach monatelanger Funkstille offiziell tot
5. Juni 2026
Mission beendet: Die US-Raumfahrtbehörde Nasa hat sich von der Marssonde »Maven« verabschiedet. Über ein Jahrzehnt hatte sie den Roten Planeten aus der Nähe erforscht – und dabei etwa besondere Polarlichter… Weiterlesen …
Blue-Origin-Rakete explodiert: Jeff Bezos hat ein Problem, das Nasa-Mondprogramm ebenso
30. Mai 2026
Ein spektakulär fehlgeschlagener Test einer Rakete von Blue Origin bringt den ohnehin optimistischen Zeitplan des US-Mondprogramms in Gefahr. Im Stillen freuen könnten sich China und Elon Musk. Quelle: SPIEGEL ONLINE… Weiterlesen …
Blue Origin: Rakete explodiert auf Startrampe in Florida
30. Mai 2026
Das Unternehmen sprach von einer »Anomalie«, YouTube zeigt einen riesigen Feuerball: Eine Rakete von Blue Origin ist bei einem Test in Flammen aufgegangen. Chef Jeff Bezos gab sich zerknirscht. Quelle:… Weiterlesen …
Artemis: Die Nasa möchte einen Drohnenschwarm zum Mond schicken
28. Mai 2026
Mondstation, Astronautenmobile, Frachtroboter: Die Nasa präsentiert aktualisierte Pläne für das US-Mondprogramm. Schon 2028 könnten Drohnen dort ein Territorium abstecken. Wie realistisch sind die Pläne? Quelle: SPIEGEL ONLINE Wissenschaft
Galaxie Loki: Astronomen stoßen in Milchstraße auf mögliche Überreste eines fremden Sternensystems
25. Mai 2026
Kommen sie von außerhalb unserer Galaxie? Astronomen haben eine Gruppe von 20 rätselhaften Sternen untersucht. Sie könnten einen gemeinsamen Ursprung haben. Quelle: SPIEGEL ONLINE Wissenschaft
Antarktis: Forscher finden im Eis Spuren einer Sternexplosion
15. Mai 2026
Jahrelang rätselten Wissenschaftler über mysteriöse Eisenatome im Schnee der Antarktis. Dank 80.000 Jahre altem Eis haben sie nun herausgefunden: Sie stammen aus einer interstellaren Wolke, durch die unser Sonnensystem gerade… Weiterlesen …
Uhrenmesse »Watches and Wonders«: Diese Modelle werden fürs Weltall entwickelt
25. April 2026
Das All ist die extremste aller Umgebungen, in denen eine Uhr funktionieren muss. Mehrere Firmen arbeiten an neuen Modellen. Doch worum geht es dabei wirklich? Quelle: SPIEGEL ONLINE Wissenschaft
Copyright © 2026 wissenschaftaktuell.de
Wir verwenden Cookies, um Ihre Erfahrung auf unserer Website zu verbessern. Durch die Nutzung unserer Website stimmen Sie der Verwendung von Cookies zu.
Verwalten Sie unten Ihre Cookie-Einstellungen:
Essenzielle Cookies ermöglichen grundlegende Funktionen und sind für das ordnungsgemäße Funktionieren der Website erforderlich.
Diese Cookies werden benötigt, um Kommentare auf dieser Website hinzuzufügen.
Diese Cookies werden zur Verwaltung der Anmeldefunktionen auf dieser Website verwendet.
Weitere Informationen finden Sie in unserem {Impressum u. Datenschutz}.
